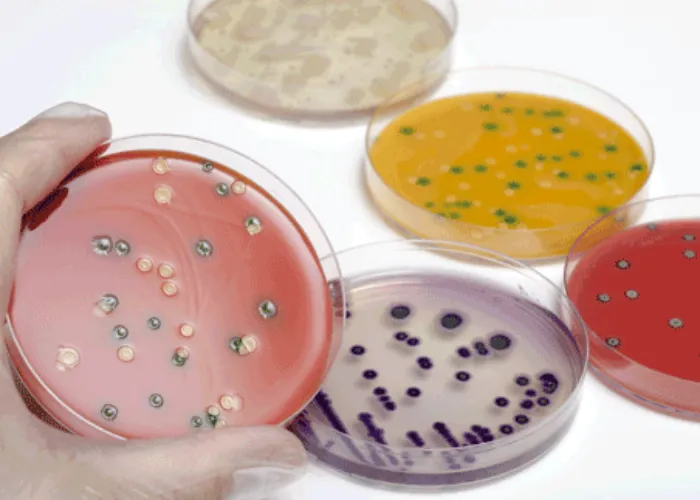

Apeks Medikal
1988 yılında medikal sektöründe hizmet vermek için konusunda uzman kişiler tarafından kurulan APEKS Medikal A.Ş., sonraki yıllarda mikrobiyoloji ve sterilizasyon alanlarında çalışmalarına yoğunluk vermiştir.
Diğer taraftan; Dünya pazarında bulunan ve Türkiye'de üretilen kaliteli ve standartlara uygun ürünleri, medikal ve sanayi kuruluşlarının ihtiyaçlarına göre, onların hizmetine en kısa sürede sunmayı hedef edinmiştir.
Firmamız, konusunda uzman, eğitimli personeli ile satış sonrası eğitim desteği de vermektedir.
Diğer taraftan; Dünya pazarında bulunan ve Türkiye'de üretilen kaliteli ve standartlara uygun ürünleri, medikal ve sanayi kuruluşlarının ihtiyaçlarına göre, onların hizmetine en kısa sürede sunmayı hedef edinmiştir.
Firmamız, konusunda uzman, eğitimli personeli ile satış sonrası eğitim desteği de vermektedir.
Devamını Gör

İletişim Bilgilerimiz
Apeks Medikal'e ulaşmak ve bilgi almak için hemen tıklayın
Bizi Yakından Tanıyın
Apeks Medikal'i yakından inceleyin, hakkımızda daha fazla bilgi sahibi olun.